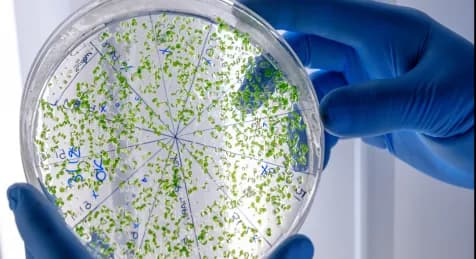
Microbiology

Every symptom, question, or doubt about your health matters. Explore a wide range of health conditions — from common to complex — and take the first step toward clarity and care.
Our Services

Hematology
Haematology is the study of blood and its disorders. It helps diagnose conditions like anemia, leukemia, and clotting problems.

Clinical Biochemistry
Biochemistry tests measure chemicals in the blood to understand organ function and detect diseases.
.webp&w=640&q=75)
Serology
Serology is the study of blood serum to detect antibodies or infections. It helps diagnose diseases like HIV, hepatitis, and COVID-19.
.webp&w=640&q=75)
Clinical Pathology
Clinical Pathology tests blood, urine, and body fluids to diagnose diseases and monitor health conditions.
.webp&w=640&q=75)
Histopathology
Histopathology is the study of tissues under a microscope to detect diseases like cancer and infections. It helps in accurate diagnosis by examining tissue samples.
Microbiology
Microbiology is the study of microorganisms like bacteria, viruses, and fungi. It helps diagnose infections and guides proper treatment.
Facilities
- 01Fully automated biochemistry analyser
- 026 part haematology analyser
- 03Immunoassay analyser
- 04HbA1c (Glycated haemoglobin) analyser
- 05Electrolyte analyser
- 06ELISA reader
Why Choose Us ?
Accuracy and reliability are vital in testing. At Noble, we ensure top quality through participation in QC programs by AIIMS, CMC Vellore, and BioRad. With expert pathologists, trained technicians, automated systems, and advanced lab software, we deliver fast, accurate, and online-accessible results.
Why Choose Us ?

Best equipments to ensure
the most reliable results

Fully automated testing
methods

Two in-house pathologists
& Well-trained technicians

All your diagnostic
requirements in one roof.